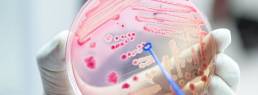

26 de agosto Día Internacional Contra el Dengue
El dengue es una enfermedad viral causada por el mosquito Aedes aegypti, y afecta cada año a más de 390 millones de personas en el mundo.
Hay que evitar tener en nuestros hogares agua acumulada, dado que el mosquito vive en todo tipo de recipientes artificiales durante sus primeros días de vida.
Recuerda: ¡Sin mosquitos no hay dengue! Y no hay vacuna que nos proteja. Tampoco insecticidas eficientes ni soluciones mágicas que eliminen al mosquito sin perjudicar el ambiente y las personas.
El síntoma más común del dengue es la fiebre junto a cualquiera de los siguientes: náuseas, vómitos, sarpullido, molestias y dolores (dolor en los ojos, generalmente detrás de los ojos, dolor muscular, dolor en las articulaciones o dolor en los huesos).
Se recomienda que las personas que tengan alguno de estos síntomas consulten a su médico para tener el tratamiento adecuado y oportuno.


"La principal lección de la pandemia de Covid-19 es que nos recuerda que la vida es incierta y que si esperamos a la certidumbre siempre llegaremos tarde"
La incertidumbre y nuestra actitud hacia ella es precisamente uno de los temas que la investigadora estadounidense ha estudiado en los últimos años. Margaret Heffernan insiste en que hay que abrazar y aceptar la incertidumbre para desarrollar resiliencia. «No podemos esperar al plan perfecto», le dice a BBC News
Pero ahora mismo, con la pandemia, la economía y el clima, estamos en un punto en el que no tenemos más tiempo para procurar pensar en cuál es ‘el resultado perfecto predecible’.
Necesitamos usar nuestra imaginación para ver qué es lo mejor, intentarlo y aprender; intentarlo otra vez y aprender más y hacer eso a medida que avanzamos y no esperar hasta tener todo esquematizado en la teoría antes de tener la energía y el coraje para hacer cualquier cosa en la práctica.
La entrevista completa aquí

Semana Mundial de la Salud asociada a las Lentes de Contacto
Desde nuestra línea Arlyt de Laboratorios Poen les brindamos consejos para concientizar sobre su adecuado uso:
- Acuérdate siempre de desinfectar tus lentes antes y después de usarlas.
- El agua y las lentes de contacto no se llevan bien. El agua puede hacer que las lentes de contacto blandas se hinchen y se peguen a los ojos. Esto puede generar molestias y complicaciones en la córnea.
- Asegúrate que la boca del frasco de la solución limpiadora que uses no entre en contacto con ninguna otra superficie.
- Usa siempre solución del frasco, no reutilices la que usaste a la mañana o a la noche.
- Recuerda que el lavado de manos es una de las acciones más importantes para el cuidado de tu salud. Mucho más hoy en día. Higieniza tus manos con agua y jabón cada vez que vas a manipular tus lentes de contacto.
- Con estos simples cuidados puedes disfrutar de tus lentes limpias y seguras
¡Con el buen uso de tus lentes, también cuidas tu salud visual!


Por qué 2020 será el año de la "economía de la confianza"
Los efectos de la pandemia en el contexto laboral subrayan la importancia cada vez mayor de la confianza. Para que el trabajo a distancia sea efectivo es necesario un mayor grado de confianza en los empleados y entre empleados y empleadores.
A largo plazo, las organizaciones que promuevan un mayor grado de confianza disfrutarán de mejores condiciones para prosperar en esta nueva era. Al fin y al cabo, el éxito del trabajo distribuido dependerá de la distribución de la confianza. No podemos esperar que «ellos» aprendan a realizar las cosas de manera diferente.
No hay «ellos»: solo estamos “nosotros”. Ahora más que nunca, las culturas organizacionales con un mayor rendimiento exigen los mejores esfuerzos y las mejores ideas de todos.
Fuente: World Economic Forum

Vínculo autismo y colesterol
Investigadores de la Harvard Medical School and Massachusetts General Hospital, el Massachusetts Institute of Technology y la Northwestern University han identificado un subtipo de autismo que surge de un grupo de genes que regulan el metabolismo del colesterol y el desarrollo cerebral.
El equipo identificó las raíces moleculares compartidas entre la disfunción de lípidos y el autismo a través del análisis de ADN de muestras cerebrales, hallazgos que luego confirmaron al examinar los registros médicos de las personas con autismo. De hecho, tanto los niños con autismo como sus padres tenían #alteraciones pronunciadas en los lípidos sanguíneos, mostró el análisis.
Los resultados del estudio publicado en Nature Medicine, dijeron los investigadores que plantean muchas preguntas:
- ¿Cómo las alteraciones de los lípidos impulsan la disfunción del desarrollo neurológico?
- ¿Cómo la normalización del metabolismo de los lípidos podría afectar los resultados de la enfermedad?
Los nuevos hallazgos preparan el escenario para que estudios futuros respondan estas preguntas y otras.

Australia se adelanta en asegurar la vacuna para su población
La Universidad de Oxford en colaboración con el laboratorio AstraZeneca han desarrollado una vacuna contra el Covid-19 que se encuentra en fases avanzadas de su desarrollo. Esto ha hecho que diversos países se pongan en carrera para conseguir las dosis en cuanto estén disponibles. Los estudios clínicos de esta vacuna se encuentran entre las fases 2 y 3, y la Unión Europea anunció recientemente un acuerdo con la farmacéutica AstraZeneca para comprar al menos 300 millones de dosis. El Reino Unido, donde se desarrolló la vacuna, comprará otros 100 millones de dosis. La semana pasada Argentina y México anunciaron también un acuerdo para fabricar y distribuir dicha vacuna en América Latina, lo que significaría un mínimo de 150 millones de dosis.
Ese es el caso de Australia, que asegurará la distribución de la vacuna para su población de 25 millones de habitantes, si es que los estudios clínicos que aún están en curso culminan exitosamente. Esto ha afirmado el primer ministro, Scott Morrison, quien asegura que si es exitosa, la vacuna será producida y distribuida en dicho país. El costo aún se desconoce, pero Australia ya ha firmado un acuerdo con la farmacéutica Becton Dickinson para el suministro de agujas y jeringas por 18 millones de dólares americanos. Morrison estableció que, si la vacuna demuestra ser eficaz y segura, espera tenerla disponible para su país a comienzos de 2021, aunque la manufactura australiana podría requerir más tiempo.
Morrison agregó que espera que la vacuna exitosa sea «tan obligatoria como sea posible», aunque su gobierno todavía está evaluando su política al respecto. «Siempre hay exenciones para cualquier vacuna por razones médicas, pero esa debe ser la única base», dijo. «Estamos hablando de una pandemia que ha destruido la economía mundial y ha cobrado la vida de cientos de miles de personas en todo el mundo, y de más de 430 australianos aquí». El país aspiraría a que el 95% de la población se vacunas. Añadió: “La vacuna de Oxford es una de las más avanzadas y prometedoras en el mundo, y con este acuerdo hemos garantizado el acceso prioritario para todos los australianos”.
Más información:
– Coronavirus vaccine: Australia secures access to Oxford-AstraZeneca trial. BBC News. 19 de Agosto 2020. Extraído de:
https://www.bbc.com/news/world-australia-53826846
– Australia producirá la vacuna de Oxford y la distribuirá gratuitamente entre sus ciudadanos. Infobae. 18 de Agosto 2019. Extraído de:
https://www.infobae.com/america/mundo/2020/08/19/australia-producira-la-vacuna-de-oxford-y-la-distribuira-gratuitamente-entre-sus-ciudadanos/?outputType=amp-type&utm_medium=Echobox&utm_source=Twitter&__twitter_impression=true
Conexion Megalabs - Australia se adelanta en asegurar la vacuna para su población

China patenta su primera vacuna contra el COVID-19
El 17 de agosto de 2020 China, con 89.477 casos confirmados y 4705 muertes hasta la fecha, aprueba su primera patente de una vacuna contra el COVID-19, llamada Ad5-nCoV, convirtiéndose en la primera vacuna en recibir el visto bueno de las autoridades del país.
La vacuna, aprobada por el gobierno en junio para uso militar, utiliza un adenovirus tipo 5 para prevenir enfermedades causadas por el SARS-CoV-2, la cepa que causa el nuevo coronavirus. La Administración Nacional de Propiedad Intelectual de China informó que la vacuna fue desarrollada por el Instituto de Biotecnología de Pekín, parte de la Academia de Ciencias Médicas Militares del gobierno, y la compañía de vacunas CanSino Biologics, fundada el 13 de enero de 2009.
Según una investigación publicada en la revista The Lancet el mes de julio, la fase II del ensayo clínico, que incluyó más de 500 personas, demostró que la vacuna es segura y que genera una respuesta inmune en la mayoría de los receptores después de una única inmunización y que la misma tiene el potencial para prevenir el COVID-19. En comparación con los más jóvenes, los participantes de mayor edad generalmente obtuvieron respuestas inmunes significativamente más bajas. Como resultado, las personas mayores podrían requerir una dosis adicional para inducir una respuesta inmune más fuerte, pero se necesitarían más investigaciones para confirmar este enfoque, según la publicación.
Cabe aclarar que ninguno de los participantes de los ensayos estuvo expuesto al virus tras la inoculación, por lo cual es demasiado pronto para saber si la vacuna protege o no contra el virus. Esto podrá verse durante la fase III, que involucra a un número mucho mayor de participantes, y está prevista que se desarrolle en Arabia Saudita. CanSino también está en conversaciones con otros países entre los que se encuentran Rusia, Brasil y Chile para realizar allí la fase III de sus ensayos.
Aunque China tiene una corta historia en el desarrollo de vacunas en comparación con EEUU y Europa, el país asiático tiene la ventaja de ser el mayor productor y consumidor de vacunas en el mundo; de acuerdo con un informe de la industria, China puede suministrar más de mil millones de dosis al año gracias a unos 40 fabricantes en todo el país.
Texto tomado de:
Autoridad Sanitaria_vacuna China

Las primeras vacunas sólo llegarían al 20% de la población mundial
CEPI (Coalition for Epidemic Preparedness Innovations), la World Health Organization y Gavi, the Vaccine Alliance se han unido para afrontar el reto de conocer y responder a la fabricación y suministro de las vacunas contra Covid19 en el mundo.
El principal reto tras la obtención de la vacuna será su producción en masa para que llegue a la mayor parte de la población mundial. Pero cada vez son más los lugares de alto riesgo por todo el planeta.
Hay 113 plantas de producción en el mundo: el 40% tienen las dos capacidades: fabrican la materia prima con la que luego se fabrica el producto final dosificado (la vacuna a administrar). India, Europa y EEUU son en ese orden las zonas con más capacidad de producción de la sustancia. Para el producto terminado (vacuna final) encabeza la capacidad de producción China y le sigue EEUU. Pueden producir hasta final de 2021 entre 2.000 y 4.000 millones de dosis de vacuna anti-Covid19.
A través del programa COVAX, la distribución se realizará de manera equitativa por países, priorizando a los trabajadores sanitarios, y luego expandiendo la vacunación hasta el 20% de la población de cada país.
Fuente: Gavi The Vaccine Alliance


Nuevo test para Covid-19: rápido, económico y solo requiere de saliva
El método más comúnmente utilizado para la detección de SARS-CoV-2 ha sido, desde el inicio de la pandemia, un hisopado nasofaríngeo con posterior análisis de PCR. Este método, aunque muy efectivo, ha generado inconvenientes a la hora de tomar la muestra puesto que es muy invasivo. La comunidad científica ha trabajado arduamente para encontrar un método alternativo, que sea menos invasivo, más económico y altamente sensible. Dado que la muestra de saliva se recoge por la propia persona, bajo la observación de un profesional de la salud, también podría reducir potencialmente el riesgo al que se exponen los trabajadores de la salud encargados de la recogida de muestras.
En el día 15 de agosto de 2020, la FDA autorizó el uso de emergencia del quinto test basado en saliva, llamado SalivaDirect® desarrollado por la Escuela de Salud Pública de Yale. ¿Cuál es la novedad de este test, si ya hay 4 test de saliva previamente autorizados? Su nuevo método de procesamiento de la muestra. Simplemente basta con colectar la muestra en cualquier contenedor que sea estéril. Además, simplificaron el test diagnóstico al (1) no requerir conservantes de ácido nucleico en la recogida de muestras, (2) sustituyendo la extracción de ácido nucleico por una simple la proteinasa K y el paso de tratamiento térmico, y (3) probando los especímenes con un doble complejo cuantitativo de transcripción reversa de PCR (RT-qPCR). Las pruebas tradicionales de Covid19 son un proceso de dos partes: una vez que se recoge la muestra, se debe extraer el ARN del virus antes de que pueda ser detectado por la técnica PCR. SalivaDirect elimina el paso de extracción, reemplazándolo «con algo que es realmente simple» comenta Nathan Grubaugh, profesor adjunto de la Escuela de Salud Pública de Yale, involucrado en el proyecto. “Añades una enzima, la calientas, así que pierdes el paso más caro y el que más tiempo consume y el más hábil».
El desarrollo de SalivaDirect como un medio para expandir rápidamente las pruebas de SARS-CoV-2 fue encabezado por Nathan Grubaugh y Anne Wyllie, investigadora científica asociada de la Escuela de Salud Pública de Yale. Después de encontrar que la saliva es un tipo de muestra prometedora para la detección del SARS-CoV-2, querían mejorar aún más el método. «Con la saliva siendo rápida y fácil de recolectar, nos dimos cuenta de que podría ser un cambio de juego en los diagnósticos de Covid-19», dijo Wyllie. Ante la urgente necesidad de realizar pruebas, el equipo de Yale estaba decidido a reducir tanto los tiempos como los costes de las pruebas, para que éstas fueran ampliamente accesibles. «Las pruebas ampliamente difundidas son críticas para nuestros esfuerzos de control. Simplificamos la prueba para que sólo cueste un par de dólares en reactivos, y esperamos que los laboratorios sólo cobren unos 10 dólares por muestra. Si se pueden implementar alternativas baratas como SalivaDirect en todo el país, es posible que finalmente podamos controlar esta pandemia, incluso antes de una vacuna», dijo Grubaugh.
Este test, el cual puede analizar 90 muestras en menos de 3 horas, está siendo validado para testear individuos que se encuentran asintomáticos pero han sido infectados por el SARS-CoV-2. SalivaDirect ya ha sido usado voluntariamente por varios equipos de jugadores de baloncesto profesionales, entre ellos la NBA, y su participación fue fundamental para obtener la Autorización de Uso de Emergencia de la FDA. Su costo, de aproximadamente 10 dólares americanos, permitirá que sea ampliamente utilizado a nivel mundial.
Más información:
– Quick and affordable saliva-based COVID-19 test developed by Yale scientists receives FDA Emergency Use Authorization. 15 de Agosto, 2020. Yale News. Extraído de:
https://news.yale.edu/2020/08/15/yales-rapid-covid-19-saliva-test-receives-fda-emergency-use-authorization?utm_source=newsletter&utm_medium=email&utm_campaign=newsletter_axiosam&stream=top
– Chantal B.F et al. SalivaDirect: Simple and sensitive molecular diagnostic test for SARS-CoV-2 surveillance. medRxiv. 2020. :
https://doi.org/10.1101/2020.08.03.20167791.t
– FDA Approves New Saliva-Based COVID-19 Test. Amanda Heidt. 17 de Agosto, 2020. The Scientist. Extraído de:
https://www.the-scientist.com/news-opinion/fda-approves-new-saliva-based-covid-19-test-67829?utm_campaign=TS_DAILY%20NEWSLETTER_2020&utm_medium=email&_hsmi=93439479&_hsenc=p2ANqtz-_snBNlIS8qWOvf3O_Ea6S3T0uf9zxp1C1DbNIfwuDaRMMMWI5cIVOfn3c7t3oqONtSCQXhj32sZIJaocJzRrbuJ5MGQQ&utm_content=93439479&utm_source=hs_email
– FDA NEWS RELEASE: Coronavirus (COVID-19) Update: FDA Issues Emergency Use Authorization to Yale School of Public Health for SalivaDirect, Which Uses a New Method of Saliva Sample Processing. FDA. 15 de Agosto de 2020. Extraído de:
https://www.fda.gov/news-events/press-announcements/coronavirus-covid-19-update-fda-issues-emergency-use-authorization-yale-school-public-health#:~:text=Today%2C%20the%20U.S.%20Food%20and,testing%20for%20COVID%2D19%20infection.
Conexion Megalabs - Test saliva covid Yale

Tasas preocupantes de resistencia a los antimicrobianos
La Union for International Cancer Control (UICC) lidera la lucha global contra el cáncer y alerta sobre la resistencia a los antimicrobianos (RAM), incluida la resistencia a los antibióticos, dado que afecta negativamente al tratamiento del cáncer y podría socavar los avances clave que se están logrando.
Las personas con cáncer son más susceptibles a las infecciones debido a la disminución de las defensas inmunitarias. Hasta 1 de cada 5 pacientes con cáncer que reciben tratamiento son hospitalizados debido a una infección y los antibióticos son la principal línea de defensa.
La resistencia a los antimicrobianos ocurre cuando los microorganismos (como bacterias, hongos, virus y parásitos) cambian y aún pueden crecer, incluso cuando están expuestos a medicamentos antimicrobianos que están destinados a matar o limitar su crecimiento (como antibióticos, antifúngicos, antivirales, antipalúdicos y antihelmínticos).
En junio 2020, la OMS expresó su preocupación sobre este tema por el uso inadecuado de antibióticos durante la pandemia de COVID-19.